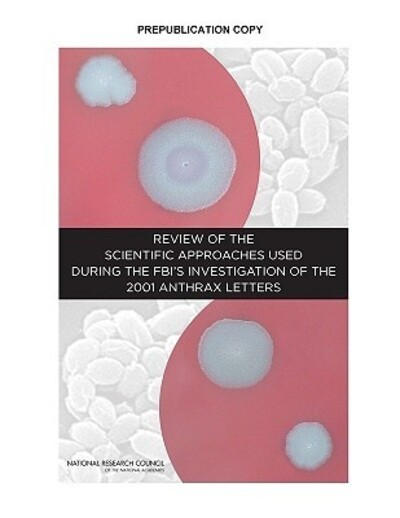

Currently Out Of Stock
Review of the scientific approaches used during the FBI's investigation of the 2001 anthrax letters
Paperback
€57.40
Collect 172 Reward Points
- Currently Out Of Stock
- Book Synopsis
- Less than a month after the September 11, 2001 attacks, letters containing spores of anthrax bacteria (Bacillus anthracis, or B. anthracis) were sent through the U.S. mail. Between October 4 and November 20, 2001, 22 individuals developed anthrax; 5 of the cases were fatal. During its investigation of the anthrax mailings, the FBI worked with other federal agencies to coordinate and conduct scientific analyses of the anthrax letter spore powders, environmental samples, clinical samples, and samp
- Product Details
-
- ISBN
- 9780309187190
- Format
- Paperback
- Publisher
- National Academies Press, (01 June 2011)
- Number of Pages
- 209
- Weight
- 499 grams
- Language
- English
- Dimensions
- 229 x 152 x 13 mm
- Categories: